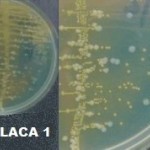
Imagem 1 - Urocultura - Amostra 1
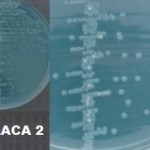
Imagem 2 - Urocultura - Amostra 2
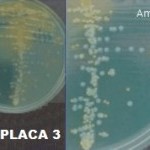
Imagem 3 - Urocultura - Amostra 3

Caso nº 1
Caso Clínico #1
Local: Curitiba-PR
Mês / Ano: Março/2001
Assuntos relacionados: Infecção do trato urinário. Criança. Sexo masculino
Quadro Clínico
A criança foi levada pela mãe ao consultório do pediatra em visita de rotina, conforme orientação anterior, para companhamento de recorrência da infecção urinária. A única queixa apresentada foi de anorexia. O exame físico não revelou febre, irritabilidade ou dor à compressão vesical mas um moderado atraso pòndero-estatural. A criança não era circuncidada e apresentava um discreto refluxo vesico-uretral, como constatado em cistouretrografia miccional realizada anteriormente. Solicitou-se realização de hemograma, urinálise de 3 amostras e urocultura de 3 amostras.
Com base nos dados clínicos e laboratoriais, propomos as seguintes questões para discussão do caso:
1) Que interpretação e seguimento você daria para cada urocultura?
2) Seria realmente necessário coletar 3 amostras de urna neste caso?
3) Quais os cuidados necessários na coleta de amostras de urina de crianças usando o saco coletor para evitar contaminação?
4) Quais bactérias poderiam ser suspeitadas na análise da morfologia colonial das 3 amostras (imagem 1 a 3)?
5) No caso de ser necessário realizar antibiograma, quais antibióticos deveriam ser testados?
6) O dado do paciente ser circuncidado é relevante para a avaliação deste caso?
7) Tendo em vista a leitura das provas da imagem 4, qual a identificação da bactéria correspondente à colônia lactose negativa?
8) Qual prova bioquímica, dentre as analisadas acima, poderia revelar resultado falso, e em qual sistema de identificação?
9) Como você interpreta os resultados da coloração de Gram das 3 amostras de urina não centrifugadas?
10) Por quê é necessário um acompanhamento freqüente, com repetição da urocultura a cada visita, em crianças assintomáticas, como é o caso deste paciente?
11) Existe alguma alteração significativa no eritrograma?
12) Como pode ser explicado o resultado da contagem diferencial?
Referências Bibliográficas
ZUNINO, Daltro. Nefrourologia Pediátrica na Prática Diária. Curitiba, Ed. da UFPR, 1993.
SILVA, Paulo Henrique & HASHIMOTO, Yoshio. Interpretação Laboratorial do Eritrograma . São Paulo, Ed. Lovise, 1999.
PILONETTO, Marcelo & PILONETTO, Daniela V. Manual de Procedimentos Laboratoriais em Microbiologia. Curitiba, Ed. Microscience, 1998.
ALBINI, Carlos Augusto. Cultura de Urina: Análise das Metodologias, Interferência sobre os Resultados e Proposta para Padronização. Monografia apresentada ao Curso de Especialização em Bacteriologia Clínica da UFPR, Curitiba, 1994.
PILONETTO, Marcelo. Avaliação de um esquema prático para a identificação presuntiva de Escherichia coli isoladas em uroculturas. Monografia presentada ao Curso de Especialização em Bacteriologia Clínica da UFPR, Curitiba, 1994.
UNIVERSIDADE FEDERAL DO PARANÁ. Manual do Laboratório. Curitiba, Hospital de Clínicas, 1990.
SOUZA, Helena A. P. H. M. A coloração de Gram como método de triagem para bacteriúria . Monografia apresentada ao Curso de Especialização em Bacteriologia Clínica da UFPR, Curitiba, 1994.
CLARRIDGE, J.E. et al. Cumitech 2A. Laboratory diagnosis of urinary tract infections. Washington, D.C., American Society for Microbiology, 1987.
Dados Laboratoriais
1) Hemograma
| Eritrócitos | 3.450.000/uL |
| Hemoglobina | 9,5g/dL |
| Volume globular | 29,0% |
| VCM | 84,0 fl |
| HCM | 27,5% |
| CHCM | 32,5% |
| Leucócitos | 11.000/uL |
| Bastonetes | 11% |
| Segmentados | 35% |
| Eosinófilos | 03% |
| Linfócitos | 45% |
| Monócitos | 06% |
| Plaquetas | 340.000/uL |
2) Urinálise
| 1ª amostra | 2ª amostra | 3ª amostra | |
| Aspecto | turva | turva | turva |
| Cor | amarelo claro | amarelo claro | amarelo claro |
| pH | 7,5 | 7,0 | 6,0 |
| Proteínas | + | + | + |
| Glicose | 0 | 0 | 0 |
| Corpos cetônicos | 0 | 0 | 0 |
| Pigmentos biliares | 0 | 0 | 0 |
| Leuc. esterase | 0 | 0 | 0 |
| Hematúria | 0 | 0 | 0 |
| Nitritos | Positivo | Positivo | Positivo |
| Leucócitos | 30/mm3 | 40/mm3 | 20/mm3 |
| Cilindros | Ausentes | Ausentes | Ausentes |
| Hemácias | Ausentes | Ausentes | Ausentes |
| Cristais | Fosf. Am. + | Ausentes | Ausentes |
| Bactérias (Gram UNC) |
BGN 8/CGA CGP 10/CGA |
BGN 2/CGA | BNV |
UNC= Urina não centrifugada; BGN= bacilos gram negativos; CGP= cocos gram positivos; CGA= campo de grande aumento ou 1000x; BNV= bacterias não visualizadas
3) Urocultura:
Semeadura de 3 amostras de urina de saco coletor colhidas em dias consecutivos.
A 1ª amostra foi coletada em casa, pela mãe, e transportada rapidamente ao laboratório, em temperatura ambiente. As outras 2 amostras foram coletadas no laboratório, seguindo orientação de pediatra.
Ver imagem 1, 2 e 3
Após a urocultura foi realizada a identificação do micro-organismos conforme imagem 4.
Respostas da discussão
1) 1ª amostra: contaminada, solicitar nova amostra. 2ª amostra: positiva para a colônia lactose-neg., identificação e antibiograma. 3ª amostra: resultado descritivo, sem identificação e sem antibiograma.
2) Sim, porque cerca de 50% dos meninos com recorrência de ITU são assintomáticos.
3) Assepsia dos genitais a cada 30-60 min. e troca do saco coletor.
4) BGN lactose-neg., provavelmente Proteus, pela história do paciente.
5) Deveriam ser testados, no mínimo: ampicilina, cefazolina (ou outra cefalosporina de 1ª geração), gentamicina, nitrofurantoína, norfloxacin e sulfametoxazol-trimetoprim.
6) Sim, porque meninos não-circuncidados têm maior tendência a infeções recorrentes por Proteus.
7) Proteus mirabilis.
8) A prova da lisina, no sistema de identificação que utiliza o meio de Rugai com lisina, devido à alcalinização do meio da base (lisina-motilidade) após a descarboxilaçao da lisina, devido à amônia produzida pela hidrólise da uréia no meio superior (Rugai), e que passa pela cera.
9) 1ª amostra: contaminada. 2ª amostra: provável ITU, com contagem superior a 100.000 colônias/mL. 3ª amostra: negativa, ou ITU com contagem inferior a 100.000/mL.
10) Porque, segundo Zunino, "...os lactentes, principalmente aqueles no primeiro ano de vida, apresentam sinais e/ou sintomas quase sempre inespecíficos. É nesta época que se estabelecem, freqüentemente, os danos renais observados evolutivamente, sempre irreversíveis."
11) Para uma criança de 11 meses a literatura relata como valor normal uma hemoglobina em torno de 11,5 a 12,0 g/dl, este é um valor médio. Aceita-se, ainda como normal, uma variação, em torno da média, entre 10 a 14,0 g/dl. Esta criança, portanto, apresenta uma anemia discreta, a qual pode ser classificada como normocítica e normocrômica. Não apresenta nenhuma alteração significativa que faça pensar em anemia hemolítica. Este eritrograma fala a favor de uma anemia normocítica e normocrômica com eritropoiese ineficaz. As infeções crônicas (infeção urinária de recorrência, no referido caso clínico) se caracterizam por ativação dos macrófagos, os quais ativados seqüestram o átomo de ferro e não o deixam disponível para a síntese de hemoglobina, com isto, o paciente estabelece um novo patamar de concentração de hemoglobina e este novo equilíbrio entre a produção (agora deficiente = ineficaz) e a destruição normal se mantém constante. Existe a possibilidade desta anemia se tornar microcítica e hipocrômica pela deficiência de ferro, não é o que ocorre comumente.
12) A interpretação do leucograma deve sempre ser feita a partir de valores absolutos. Os valores relativos (obtidos na contagem diferencial) servem para calcular o valor absoluto. Somente o número de bastonetes é interpretado pelo valor relativo. A dificuldade de se interpretar o leucograma é a variação leucocitária nas doenças e mesmo na pessoa hígida e, também, a falta de um valor normal para cada pessoa. Aceita-se para um adulto normal uma variação, do número de leucócitos, entre 4.500 a 11.000 leucócitos / m l. Para uma pessoa que tenha, como valor normal 5.000 leucócitos / m l, uma contagem de 11.000 leucócitos / m l é uma leucocitose bastante acentuada. Para a criança em questão aceita-se um valor normal médio de leucócitos em torno de 11.400, com uma variação entre 6 a 17.500 leucócitos / m l. De qualquer modo, para nossos parâmetros inter-relativos (clinicamente), 11.000 leucócitos / m l é uma leucócitose discreta. Tem-se neste caso, uma discreta leucocitose com um discreto desvio nuclear à esquerda, sem alterações como neutrofilia ou neutropenia, linfocitose ou linfopenia e não apresenta monocitose. Este é um hemograma condizente com uma infeção crônica, a medula óssea aumentou sua produção leucocitária (11% de bastonetes e 11.000 leucócitos) e estabeleceu um novo equilíbrio entre a produção leucocitária e a necessidade tecidual de leucócitos.
Obs.: BGN = bacilo gram-negativo; ITU = infeção do trato urinário.